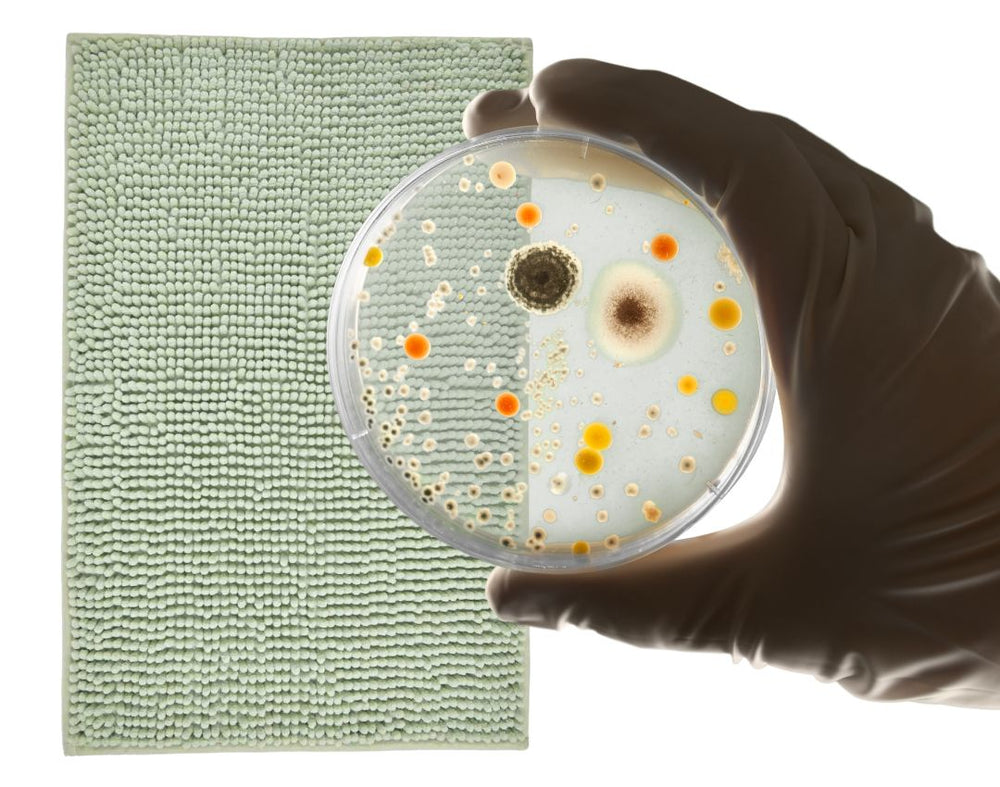

Stone Bath Mat
$59.00
Save 20%The bath mat you really need.
Natural diatomite stone mat – free from chemicals and plastics.





Stone Bath Mat

love our Stone Bath Mat.
$59.00
Save 20% Diatomite is a natural sedimentary rock composed of fossilized algae. It has the ability to absorb moisture in seconds and release it just as quickly. This keeps the surface dry and slip-resistant at all times.
Completely without chemicals – using only the power of nature – the stone mat ensures a clean, hygienic and pleasant feeling in the bathroom.
Diatomite is a natural sedimentary rock composed of fossilized algae. It has the ability to absorb moisture in seconds and release it just as quickly. This keeps the surface dry and slip-resistant at all times.
Completely without chemicals – using only the power of nature – the stone mat ensures a clean, hygienic and pleasant feeling in the bathroom.
Our diatomite bath mat is extremely durable and designed for everyday use. The material is scratch-resistant, dimensionally stable, and shows minimal wear.
Unlike conventional fabric mats, it retains its function and elegant appearance for years – a sustainable investment for your home.
Our diatomite bath mat is extremely durable and designed for everyday use. The material is scratch-resistant, dimensionally stable, and shows minimal wear.
Unlike conventional fabric mats, it retains its function and elegant appearance for years – a sustainable investment for your home.
Cleaning is straightforward: simply rinse with water or wipe with a damp cloth. For heavier soiling, the surface can be lightly sanded with the included sandpaper.
No chemical cleaners are needed – the mat dries completely within a few minutes and is immediately ready for use again.
Cleaning is straightforward: simply rinse with water or wipe with a damp cloth. For heavier soiling, the surface can be lightly sanded with the included sandpaper.
No chemical cleaners are needed – the mat dries completely within a few minutes and is immediately ready for use again.
Size: 60 × 39 × 0.87 cm
Height with anti-slip mat: 10 mm
Compact, functional and ideal for any bathroom.
Size: 60 × 39 × 0.87 cm
Height with anti-slip mat: 10 mm
Compact, functional and ideal for any bathroom.
Our stone mat is made from purely natural materials and is free of plastics or harmful additives.
The long lifespan reduces waste and energy consumption, while the environmentally friendly production makes a conscious contribution to a more sustainable everyday life.
Our stone mat is made from purely natural materials and is free of plastics or harmful additives.
The long lifespan reduces waste and energy consumption, while the environmentally friendly production makes a conscious contribution to a more sustainable everyday life.
Delivery: Fast shipping from our German warehouse.
Delivery time: Germany: 1–2 working days · EU: 2–6 working days.
Shipping costs: Free for orders over €100.
Returns: 14-day money-back guarantee – try the WimSpa Ice Pod risk-free.
Delivery: Fast shipping from our German warehouse.
Delivery time: Germany: 1–2 working days · EU: 2–6 working days.
Shipping costs: Free for orders over €100.
Returns: 14-day money-back guarantee – try the WimSpa Ice Pod risk-free.
Can I use the mat outside the bathroom?
Yes, it is ideal for kitchens, pool areas or other humid environments where quick drying is important.
How do I clean the stone mat properly?
Simply rinse with water or wipe with a damp cloth. Lightly sand if necessary.
What happens if the mat arrives damaged?
Should transport damage occur despite secure packaging, we will of course replace the mat free of charge.
Can I use the mat outside the bathroom?
Yes, it is ideal for kitchens, pool areas or other humid environments where quick drying is important.
How do I clean the stone mat properly?
Simply rinse with water or wipe with a damp cloth. Lightly sand if necessary.
What happens if the mat arrives damaged?
Should transport damage occur despite secure packaging, we will of course replace the mat free of charge.
WimSpa is a German company based near Cologne.
We stand for quality, durability and personal service – no dropshipping products, but our own tested goods.
Our diatomite stone slab and ice pod are designed for durability and are shipped with great care.
Our customer support is always there for you if you have any questions or need assistance.
WimSpa is a German company based near Cologne.
We stand for quality, durability and personal service – no dropshipping products, but our own tested goods.
Our diatomite stone slab and ice pod are designed for durability and are shipped with great care.
Our customer support is always there for you if you have any questions or need assistance.
Stone Bath Mat
$59.00
Regular price $47.00 Diatomite is a natural sedimentary rock composed of fossilized algae. It has the ability to absorb moisture in seconds and release it just as quickly. This keeps the surface dry and slip-resistant at all times.
Completely without chemicals – using only the power of nature – the stone mat ensures a clean, hygienic and pleasant feeling in the bathroom.
Diatomite is a natural sedimentary rock composed of fossilized algae. It has the ability to absorb moisture in seconds and release it just as quickly. This keeps the surface dry and slip-resistant at all times.
Completely without chemicals – using only the power of nature – the stone mat ensures a clean, hygienic and pleasant feeling in the bathroom.
Our diatomite bath mat is extremely durable and designed for everyday use. The material is scratch-resistant, dimensionally stable, and shows minimal wear.
Unlike conventional fabric mats, it retains its function and elegant appearance for years – a sustainable investment for your home.
Our diatomite bath mat is extremely durable and designed for everyday use. The material is scratch-resistant, dimensionally stable, and shows minimal wear.
Unlike conventional fabric mats, it retains its function and elegant appearance for years – a sustainable investment for your home.
Cleaning is straightforward: simply rinse with water or wipe with a damp cloth. For heavier soiling, the surface can be lightly sanded with the included sandpaper.
No chemical cleaners are needed – the mat dries completely within a few minutes and is immediately ready for use again.
Cleaning is straightforward: simply rinse with water or wipe with a damp cloth. For heavier soiling, the surface can be lightly sanded with the included sandpaper.
No chemical cleaners are needed – the mat dries completely within a few minutes and is immediately ready for use again.
Size: 60 × 39 × 0.87 cm
Height with anti-slip mat: 10 mm
Compact, functional and ideal for any bathroom.
Size: 60 × 39 × 0.87 cm
Height with anti-slip mat: 10 mm
Compact, functional and ideal for any bathroom.
Our stone mat is made from purely natural materials and is free of plastics or harmful additives.
The long lifespan reduces waste and energy consumption, while the environmentally friendly production makes a conscious contribution to a more sustainable everyday life.
Our stone mat is made from purely natural materials and is free of plastics or harmful additives.
The long lifespan reduces waste and energy consumption, while the environmentally friendly production makes a conscious contribution to a more sustainable everyday life.
Delivery: Fast shipping from our German warehouse.
Delivery time: Germany: 1–2 working days · EU: 2–6 working days.
Shipping costs: Free for orders over €100.
Returns: 14-day money-back guarantee – try the WimSpa Ice Pod risk-free.
Delivery: Fast shipping from our German warehouse.
Delivery time: Germany: 1–2 working days · EU: 2–6 working days.
Shipping costs: Free for orders over €100.
Returns: 14-day money-back guarantee – try the WimSpa Ice Pod risk-free.
Can I use the mat outside the bathroom?
Yes, it is ideal for kitchens, pool areas or other humid environments where quick drying is important.
How do I clean the stone mat properly?
Simply rinse with water or wipe with a damp cloth. Lightly sand if necessary.
What happens if the mat arrives damaged?
Should transport damage occur despite secure packaging, we will of course replace the mat free of charge.
Can I use the mat outside the bathroom?
Yes, it is ideal for kitchens, pool areas or other humid environments where quick drying is important.
How do I clean the stone mat properly?
Simply rinse with water or wipe with a damp cloth. Lightly sand if necessary.
What happens if the mat arrives damaged?
Should transport damage occur despite secure packaging, we will of course replace the mat free of charge.
WimSpa is a German company based near Cologne.
We stand for quality, durability and personal service – no dropshipping products, but our own tested goods.
Our diatomite stone slab and ice pod are designed for durability and are shipped with great care.
Our customer support is always there for you if you have any questions or need assistance.
WimSpa is a German company based near Cologne.
We stand for quality, durability and personal service – no dropshipping products, but our own tested goods.
Our diatomite stone slab and ice pod are designed for durability and are shipped with great care.
Our customer support is always there for you if you have any questions or need assistance.
7 Chakra Scented Candle Set with Crystals
$35.00






Grounding Bedsheet made of Cotton with Silver Threads
$82.00












Dries in seconds
The Stone Plate absorbs water in seconds and dries completely without leaving any residue. This keeps your bathroom clean and hygienic at all times – without damp towels or musty smells. A modern upgrade for your daily wellness routine.
Trocknet blitzschnell

Hygiene on a new level
Lab-tested and proven in everyday use: The Stone Plate remains hygienically clean even after months of use. Thanks to its antibacterial properties and non-porous surface, it dries faster than any conventional bath mat – leaving germs no chance. The stylish and safe choice for a clean bathroom.
Stone mat in direct comparison

Stone Plate

Made from natural materials
Naturally antibacterial
Fast water absorption and
Dries fast without sagging
Long-lasting and durable
Conventional bath mats

Made from synthetic materials
Prone to bacteria and odor
Slow to absorb and dry
Wears out quickly and
needs frequent replacement

A journey from the South of France to your bathroom
A journey from Southern France in your bathroom
The inspiration for the Wim Spa stone mat came from a personal experience our founder Steven had while traveling. In October 2023, he discovered the beneficial routine of ice baths in the sea on the tranquil beaches of southern France. The stony beach offered a surprising detail – after each dip, his feet were instantly dry, thanks to the natural absorbency of the stones. This observation became the starting point for an idea.
Steven realized that this natural functionality and simplicity could also be applied to the bathroom. He wanted to create a bath mat that used the same principle – quick-drying, hygienic, and sustainable. This is how the Stone Plate concept was born.
For its realization, he discovered diatomite – a natural mineral material formed from fossilized algae. It is not only environmentally friendly but also extremely absorbent and dries faster than conventional bath mats. Perfect for a modern, clean, and sustainable bathroom experience.
Inspired by nature, developed for your well-being
Wellbeing
We use durable, environmentally friendly materials and avoid unnecessary packaging. Every Ice Pod is designed to conserve resources – from product to shipping.
Precision, functionality, and durability are at the heart of every design. The Ice Pod combines German engineering with modern wellness technology.
WimSpa stands for balance of body and mind. Our products promote regeneration, energy and mental strength – inspired by nature.
We use durable, environmentally friendly materials and avoid unnecessary packaging. Every Ice Pod is designed to conserve resources – from product to shipping.
Precision, functionality, and durability are at the heart of every design. The Ice Pod combines German engineering with modern wellness technology.
WimSpa stands for balance of body and mind. Our products promote regeneration, energy and mental strength – inspired by nature.














